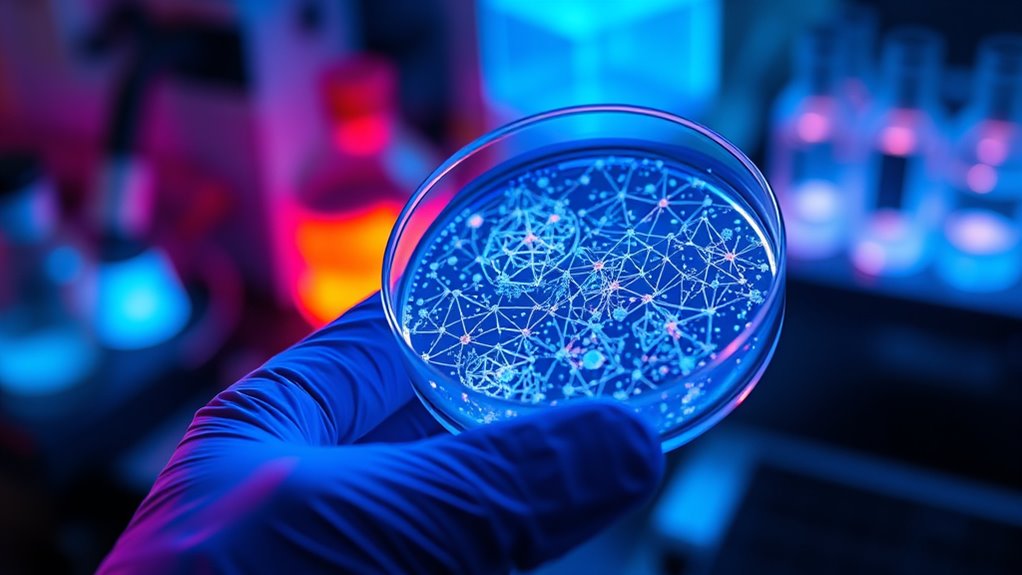
nanotech improves health and environment

Nanotech terminology builds around core concepts like nanoparticles, nanomaterials, and nanostructures, which are materials measured in nanometers — billionths of a meter — giving them unique properties. You’ll encounter terms like top-down and bottom-up manufacturing, which involve different ways to build tiny structures, and tools like electron microscopes and atomic force microscopes that let you see at this scale. Understanding these buzzwords helps you grasp how nanotechnology is shaping future innovations across medicine, environment, and electronics.
Key Takeaways
- Nanotechnology involves manipulating matter at the 1-100 nanometer scale, where materials exhibit unique quantum properties.
- Common nanomaterials include nanoparticles, nanowires, nanofilms, nanorods, and nanocrystals, each with specific applications.
- Visualization tools like TEM, STM, and AFM are essential for observing and manipulating nanoscale structures.
- Bottom-up and top-down approaches are key strategies in constructing nanostructures, focusing on assembly or etching.
- Nanotech applications span medicine, environmental cleanup, electronics, and energy, driven by the unique properties of nanoscale materials.

Transmission Electron Microscopy: A Textbook for Materials Science (4 Vol set)
As an affiliate, we earn on qualifying purchases.
As an affiliate, we earn on qualifying purchases.
Understanding the Nanoscale: What Does It Really Mean?

Have you ever wondered what makes the nanoscale so special? It’s all about size—measured in nanometers, which is one-billionth of a meter. To put that in perspective, a nanometer is about 100,000 times smaller than the width of a human hair. Nanotechnology focuses on understanding and controlling matter at these tiny dimensions, typically between 1 and 100 nanometers. At this scale, materials exhibit unique properties that differ from their larger counterparts. For example, nanoparticles can have different optical, electrical, or chemical behaviors because of quantum effects. Structures at the nanoscale are so small that classical physics no longer fully explains their behavior. This tiny world opens up exciting possibilities for innovations across medicine, electronics, and materials science, especially through precise control of matter at the nanoscale. Additionally, these properties enable the development of advanced materials that can be used in various smart applications, including those in modern homes. In fact, understanding nanoscale properties is crucial for designing effective nanomaterials and harnessing their full potential.

Fluorocrystalline Mica Sheet for AFM Atomic Force Microscope, 5PCS AFM Infrared Window, Nanometer Material Microscope Substrate, No Surface Interference Fringes (10X10X0.2mm)
💯Fluorocrystalline mica can be used in electrical insulation, high-frequency medium, high temperature and vacuum, high temperature and high…
As an affiliate, we earn on qualifying purchases.
As an affiliate, we earn on qualifying purchases.
Key Types of Nanomaterials and Their Unique Features

Nanomaterials come in various forms, each with distinct features that set them apart from bulk materials. You’ll find nanoparticles, nanorods, nanowires, nanofilms, nanocomposites, and nanocrystals, all designed for specific functions. Nanoparticles, with at least one dimension under 100 nanometers, exhibit unique optical, electrical, and chemical properties due to quantum effects. Their size-dependent properties enable applications that are impossible with larger particles. Additionally, the synthesis methods of nanomaterials influence their characteristics and potential uses. Nanowires and nanorods provide high surface area and conductivity, ideal for electronics and sensors. Nanofilms are ultra-thin layers used in coatings and electronics, offering transparency and durability. Nanocomposites combine different nanomaterials to enhance strength, flexibility, or conductivity. Nanocrystals, with ordered crystalline structures, are key in catalysis and medicine. Understanding nanotechnology is essential for recognizing how these materials can revolutionize various industries and lead to innovative applications. Moreover, advances in characterization techniques help scientists better understand and optimize these materials for specific uses. Recognizing these types helps you understand how their unique features access innovative applications across industries.

ALDON Innovating Science Green Nanochemistry: Synthesis of Silver Nanoparticles Kit
Synthesize silver nitrate nanoparticles using renewable materials
As an affiliate, we earn on qualifying purchases.
As an affiliate, we earn on qualifying purchases.
Tools and Techniques for Seeing the Nanoscale World

How do scientists actually see objects at the nanoscale? They use advanced tools that detect and visualize tiny structures with incredible detail. Transmission Electron Microscopy (TEM) directs high-energy electrons through samples, revealing atomic arrangements. Scanning Tunneling Microscopes (STM) scan conducting surfaces, producing atomic images. Atomic Force Microscopes (AFM) use a sharp tip to feel surface topography at the nanoscale. NanoManipulator combines VR and force feedback to interact with individual atoms. These tools are essential in nanotech visualization, enabling researchers to explore the nanoscale world with precision.
nanotech visualization tools
As an affiliate, we earn on qualifying purchases.
As an affiliate, we earn on qualifying purchases.
Exploring Nanoelectronics and Nanoelectromechanical Systems

Nanoelectronics and nanoelectromechanical systems (NEMS) harness the unique properties of materials at the nanoscale to create devices with unprecedented performance and miniaturization. You’ll experience how these systems push boundaries, enabling faster, smaller, and more efficient technology. Imagine:
- Transforming everyday gadgets into sleek, powerful tools that fit in your pocket.
- Revolutionizing healthcare with nanoscale sensors that detect diseases early.
- Making communication faster through ultra-compact transistors and circuits.
- Unlocking new scientific discoveries with devices that manipulate atoms and molecules.
These innovations open doors to a future where devices are not only smaller but smarter, more responsive, and capable of previously impossible tasks. You become part of a revolution that shapes technology at the very smallest scale. Understanding material properties at the nanoscale is fundamental to advancing these technologies and achieving their full potential.
Methods for Building at the Nanoscale: Top-Down and Bottom-Up Approaches

You can build nanoscale structures using material removal strategies or atomic-level assembly techniques. Top-down methods start with larger materials and shape them down to size, while bottom-up approaches assemble structures from individual atoms or molecules. Understanding these methods helps you choose the best approach for precise nanomanufacturing goals. Additionally, advancements in best CAD papers are facilitating more accurate design and simulation processes in nanotechnology fabrication.
Material Removal Strategies
Material removal strategies at the nanoscale focus on two main approaches: top-down and bottom-up methods. With top-down processes, you carve away material from larger structures, revealing intricate features and precise shapes. Conversely, bottom-up techniques build structures atom-by-atom or molecule-by-molecule, allowing for atomic precision. When choosing your strategy, consider these key points:
- Control and Precision—Gain fine control over nanoscale features.
- Complexity—Build complex structures or refine existing ones.
- Efficiency—Optimize time and material use.
- Application Suitability—Match methods to your project’s goals and scale.
Additionally, understanding the sound healing science behind certain techniques can enhance the effectiveness of therapeutic applications in nanotech-based medical devices.
Understanding these strategies enables you to harness nanotechnology’s full potential, whether you’re sculpting tiny devices or assembling molecular components.
Atomic-Level Assembly Techniques
Building at the nanoscale requires precise assembly methods that can be broadly categorized into top-down and bottom-up approaches. In top-down techniques, you start with a larger material and remove sections to achieve the desired nanoscale structures, similar to sculpting a block of stone. This approach includes methods like etching and lithography, which carve away material with high precision. Conversely, bottom-up methods build structures atom-by-atom or molecule-by-molecule, like assembling a puzzle from small pieces. Self-assembly and chemical synthesis are key examples, where molecules naturally organize into desired patterns based on chemical bonds and interactions. Incorporating designer aesthetics into nanostructures can also optimize their function and system integration, leading to more efficient and innovative nanodevices. Additionally, understanding material properties at the atomic level is crucial for tailoring nanostructures to specific applications. Developing techniques to control intermolecular forces enhances the ability to create complex and functional nanostructures with atomic accuracy, which is essential for advancing nanotechnology applications across electronics, medicine, and materials science.
Fields Transforming With Nanotechnology: From Medicine to Environment
Nanotechnology is rapidly changing how we approach medicine and environmental issues. You’ll see faster medical breakthroughs and more effective ways to clean up pollutants. These advancements are shaping a smarter, healthier future for everyone. Additionally, nanotech innovations are making it easier to develop pest-free gardens and promote healthy plant growth.
Medical Breakthroughs Accelerated
Advancements in nanotechnology are rapidly transforming the medical field, enabling breakthroughs that were once unimaginable. You could soon experience personalized treatments, where nanomaterials target disease at the cellular level. Consider these powerful developments:
- Targeted drug delivery—nanoparticles precisely reach affected cells, reducing side effects and increasing effectiveness.
- Early disease detection—nano-sensors identify biomarkers at tiny concentrations, catching illnesses sooner.
- Regenerative medicine—nanostructures promote tissue repair and even grow new organs.
- Nanosurgical tools—minuscule instruments perform surgeries with minimal invasion, speeding recovery.
These innovations promise a future where medical care is faster, safer, and more effective, dramatically improving your health outcomes and quality of life.
Environmental Cleanup Advancements
As nanotechnology continues to revolutionize medicine, its impact extends far beyond healthcare into environmental cleanup efforts. Nanomaterials like nanoparticles and nanocomposites target pollutants at a molecular level, making cleanup more efficient. You can see this in action through nanofiltration, which removes toxins from water, or nanocatalysts that break down hazardous chemicals. These advancements enable faster, more precise remediation. Below is a table illustrating key nanotech tools used:
| Tool | Function | Application |
|---|---|---|
| Nanoparticles | Absorb, degrade, or immobilize pollutants | Water purification |
| Nanoporous materials | Capture and filter contaminants | Soil remediation |
| Nano-catalysts | Accelerate chemical reactions to detoxify waste | Industrial waste cleanup |
How Nanoparticles and Nanocrystals Impact Everyday Life

Nanoparticles and nanocrystals have become integral to many products you use daily, often without realizing it. They enhance your everyday items in powerful ways:
- Protect your skin with sunscreens containing nanocrystals that block UV rays effectively.
- Keep your food fresh longer with packaging embedded with nanomaterials that prevent spoilage.
- Improve your electronics by making devices smaller, faster, and more durable using nano-sized components.
- Ensure cleaner water through filtration systems utilizing nanoporous materials that trap contaminants.
- They also play a crucial role in outdoor cooking appliances, enhancing durability and heat efficiency of materials used in backyard pizza ovens and accessories.
These tiny structures revolutionize industries, making products safer, more efficient, and longer-lasting. Their presence quietly transforms your daily routines, improving quality of life without you even noticing it.
The Future of Nanomanufacturing and Its Potential Applications

The evolving landscape of nanomanufacturing promises to revolutionize how products are made and utilized across industries. You’ll see more precise, efficient, and sustainable processes that enable atomic-level control. In medicine, nanomanufacturing could produce targeted drug delivery systems and advanced diagnostics, transforming healthcare. In electronics, it will allow for smaller, faster, and more powerful devices, including ultra-efficient transistors and sensors. Environmental applications will benefit from nanomaterials for pollution cleanup and water purification. You might also encounter nanostructured materials in energy storage, such as high-capacity batteries and lightweight solar cells. As manufacturing methods evolve—through self-assembly, top-down, and bottom-up techniques—you’ll notice smarter, more adaptable products. Ultimately, nanomanufacturing will discover innovations that improve quality of life, sustainability, and technological progress across multiple sectors. Additionally, advances in precise control at the atomic level will enable the development of novel materials with tailored properties for specific uses. Furthermore, the integration of nanofabrication techniques will facilitate the mass production of complex nanostructures, making advanced nanotechnology more accessible and scalable. Breakthroughs in atomic-scale engineering will accelerate the creation of custom nanomaterials designed for specialized applications.
Frequently Asked Questions
How Do Quantum Effects Change Nanoparticle Properties Compared to Bulk Materials?
When you work with nanoparticles, quantum effects considerably change their properties compared to bulk materials. You’ll notice that electrons become confined, altering electrical, optical, and chemical behaviors. This means nanoparticles can be more reactive, have different colors, or conduct electricity differently. These quantum effects give you the ability to tailor materials for specific applications, like targeted drug delivery or advanced sensors, making nanotechnology powerful and versatile.
What Are the Safety Concerns Associated With Nanomaterials in Consumer Products?
You should be aware that nanomaterials in consumer products pose safety concerns like potential toxicity, inhalation risks, and environmental impact. Because nanoparticles can penetrate skin or lungs and accumulate in organs, they may cause health issues. Additionally, their environmental persistence raises worries about pollution. It’s essential to stay informed about ongoing research and regulatory guidelines to protect yourself and the environment from possible nanomaterial hazards.
How Does Self-Assembly Enable Precise Nanoscale Manufacturing?
Self-assembly enables precise nanoscale manufacturing by allowing molecules to spontaneously organize into desired structures, guided by chemical bonds and interactions. It simplifies complex fabrication processes, reduces the need for external manipulation, and guarantees uniformity. You can harness this natural process to build intricate nanomaterials, create consistent nanostructures, and develop innovative devices, all while minimizing errors, maximizing efficiency, and achieving extraordinary control at the atomic level.
In What Ways Can Nanotechnology Revolutionize Environmental Cleanup Efforts?
Nanotechnology can revolutionize environmental cleanup by creating nanomaterials that efficiently remove pollutants from air, water, and soil. You can design nanoporous filters that trap toxins or use nanoremediation to break down hazardous substances at the molecular level. With precise control over nanomaterials, you’ll develop eco-friendly, targeted solutions that are faster and more effective, ultimately reducing environmental damage and promoting healthier ecosystems worldwide.
What Challenges Exist in Scaling Nanomanufacturing for Commercial Production?
You face challenges in scaling nanomanufacturing for commercial production due to precise control requirements, high costs, and complex equipment. Ensuring consistent quality across large volumes can be difficult, and safety concerns might slow regulatory approval. Additionally, developing efficient, cost-effective methods like top-down or bottom-up approaches needs innovation. Overcoming these hurdles is essential for making nanotech products viable and widespread in markets.
Conclusion
Now that you’ve decoded the buzzwords, you can see how nanotech is shaping our world, from medicine to electronics. With tools that reveal the tiny universe and methods to build at the nanoscale, the possibilities are endless. Imagine a future where everything’s smarter, cleaner, and more efficient—can you picture it? As you explore nanotechnology’s potential, you become part of a groundbreaking journey that’s transforming everyday life in ways you never imagined.